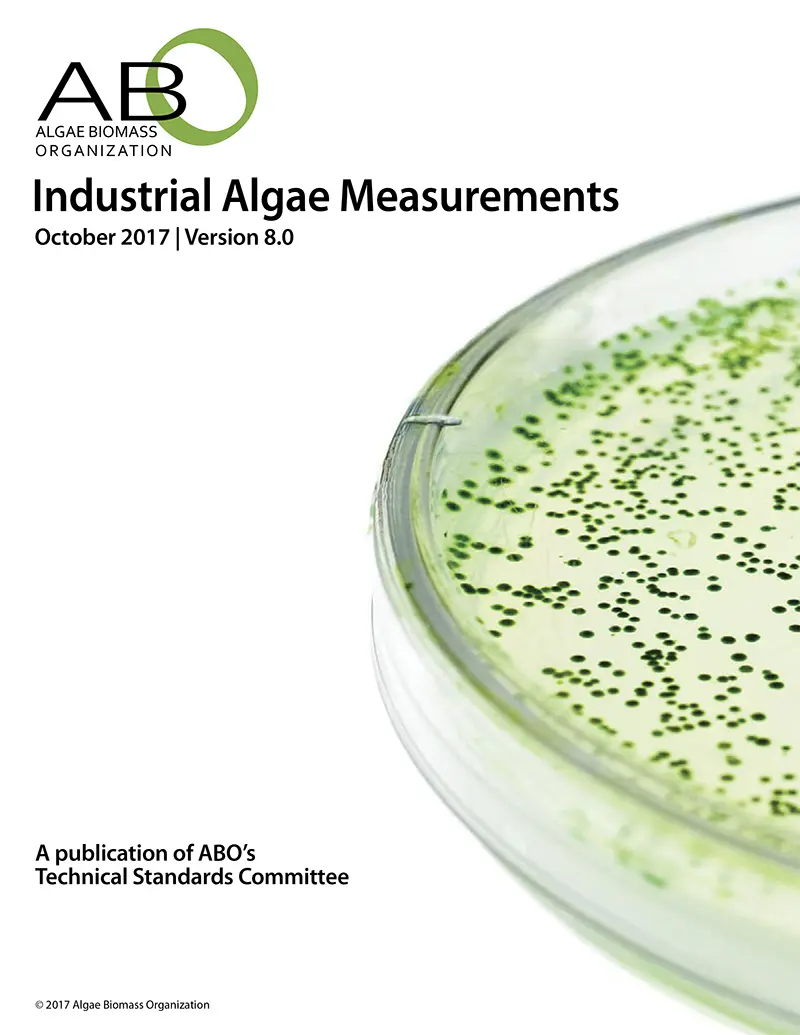

Technical Standards
Industrial Algae Measurements v. 8.0
The goal of this document is to provide an overview of the current state of the art of measurements or metrics, as well as policy and regulatory environments that are pertinent to the development and growth of a successful algal industry.The descriptive parameters listed in this document are designed to provide the industry and academic groups with a common language and direct and objective parameters for the evaluation of technologies currently on track to be commercialized.
Dedicated to Mary Rosenthal
As first Executive Director of the ABO, Mary championed the development of technical standards in our still nascent industry. When ABO started it was no more than a small group of like-minded engineers,entrepreneurs, and scientists who saw the need to have an organization promoting the use of algal biomass and the growth of an algae industry to produce it. Mary helped champion the Technical Standards Committee into what it is today.








